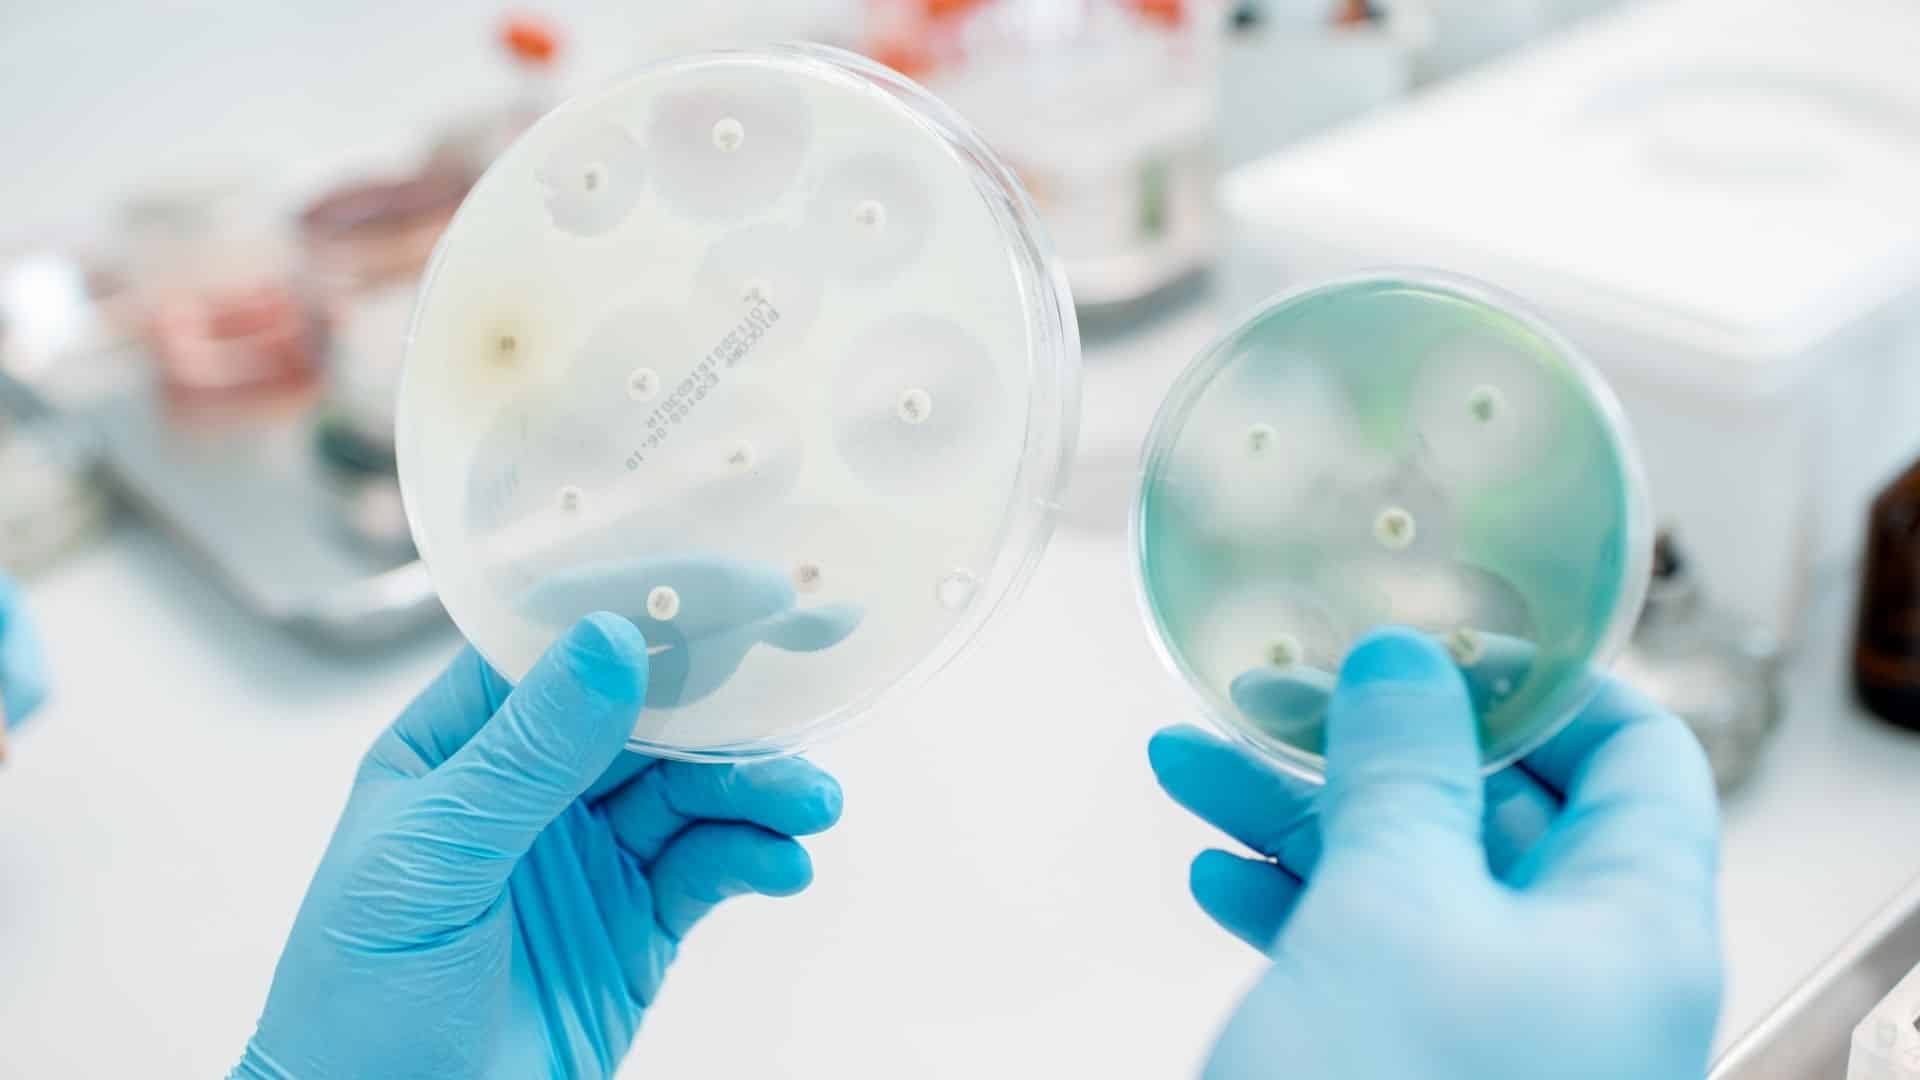
fungo

A preocupação com o meio ambiente, o aumento da demanda por alimentos saudáveis e as dificuldades para o controle químico de algumas doenças em determinados cultivos comerciais têm motivado os agricultores a adotarem estratégias alternativas para conter pragas e doenças na agricultura
Uma dessas estratégias é utilizar um fungo do bem, capaz de controlar outros fungos que causam severos prejuízos em plantios comerciais.
Estes fungos do bem são do gênero Trichoderma. Além de terem grande potencial para controle biológico de fungos causadores de doenças nas plantas, ajudam a melhorar aspectos do cultivo. A Secretaria de Agricultura e Abastecimento do Estado de São Paulo, por meio do Instituto Biológico (IB-APTA), desenvolve pesquisas nessa área e mantém uma das mais importantes coleções de Trichoderma do Brasil, que pode ser usada para o desenvolvimento de novos produtos comerciais.
De acordo com o pesquisador do IB, Ricardo Harakava, a coleção de Trichoderma do IB possui 120 isolados, ou seja, linhagens de Trichoderma, coletadas em diferentes biomas paulistas pela pesquisadora aposentada do IB, Cleusa M. M. Lucon.
“Esses isolados foram coletados em 40 locais, como na região da Mata Atlântica e Cerrado, além de diferentes áreas de vegetação nativa. O diferencial da nossa coleção é que todos esses isolados passaram por testes para verificar se promovem controle de doenças ou se agem no crescimento das plantas”, conta o pesquisador que atualmente é curador do espaço do Instituto.
Empresas produtoras de bioinsumos podem, segundo Harakava, firmar parcerias com o Instituto Biológico para utilizarem essas linhagens para o desenvolvimento de produtos para o setor de produção.
“Os produtores ou cooperativas que tiverem interesse também podem firmar esse tipo de parceria. Ocorre que o desenvolvimento desses produtos custa caro e precisam de aprovação do Ministério da Agricultura, Pecuária e Abastecimento (MAPA)”, explica.
O que são Trichoderma?
Os Trichoderma são fungos de crescimento rápido que podem ser utilizados em diversos tipos de indústria, como a de papel, alimentos, química e farmacêutica e, mais recentemente, na produção agrícola, como soja, cana-de-açúcar, algodão e olerícolas, entre outras. Eles controlam doenças causadas por fungos de solo, que infectam as raízes, a base dos caules e o sistema vascular das plantas, ocasionando podridões e murchas.
O uso do Trichoderma nas lavouras também traz outros benefícios associados ao crescimento das plantas e à produtividade, principalmente quando aplicados em solos considerados pobres em nutrientes. Os pesquisadores explicam que ao melhorar o desenvolvimento das raízes, esses fungos acabam propiciando o melhor aproveitamento de água pelas plantas e uma maior absorção de nutrientes minerais.
LEIA TAMBÉM: RESÍDUO DO TRATAMENTO DE ESGOTO DE PIRACICABA PODERÁ SE TORNAR FERTILIZANTE ORGÂNICO PARA AGRICULTURA
Os ácidos produzidos pelo Trichoderma colaboram para a solubilização de fosfatos, micronutrientes e alguns minerais como ferro, manganês e magnésio. Além disso, como participam da decomposição de matéria orgânica no solo, aumentam a quantidade de nutrientes que podem ser absorvidos pelas raízes. Algumas linhagens produzem ainda um hormônio de crescimento.
“Mas é importante lembrar que o efeito de Trichoderma na produtividade varia de acordo com a planta cultivada e a linhagem introduzida, bem como com as práticas culturais adotadas pelo produtor que podem ou não favorecer o crescimento e sobrevivência do fungo no local”, explica o pesquisador do IB.
O Instituto Biológico disponibiliza gratuitamente a cartilha online “Trichoderma: O que é, para que serve e como usar corretamente na lavoura”.
Controle biológico
O controle biológico consiste no uso de inimigos naturais para diminuir a população de uma praga. Resumidamente, pode ser definido como natureza controlando natureza. Os agentes de controle biológico agem em um alvo específico, não deixam resíduos nos alimentos, são seguros para o trabalhador rural, protegem a biodiversidade e preservam os polinizadores.
O IB é referência no Brasil e no mundo em controle biológico e tem forte atuação junto ao setor produtivo, tendo orientado a criação e manutenção das biofábricas, que desenvolvem esses produtos biológicos para serem aplicados nas lavouras. Ao todo, mais de 80 biofábricas de todo o Brasil recebem orientação dos pesquisadores do IB. Em 2019, o Instituto assinou 23 contratos para transferência de tecnologia a essas empresas, localizadas em São Paulo, Minas Gerais, Mato Grosso e Paraná.
O Instituto mantém o Programa de Inovação e Transferência de Tecnologia em Controle Biológico (Probio), que reúne as tecnologias e serviços prestados no Instituto, principalmente para as culturas da cana-de-açúcar, soja, banana, seringueira, flores, morango, feijão e hortaliças.
Fonte: Abastecimento e Agricultura – Governo do Estado de São Paulo.























































